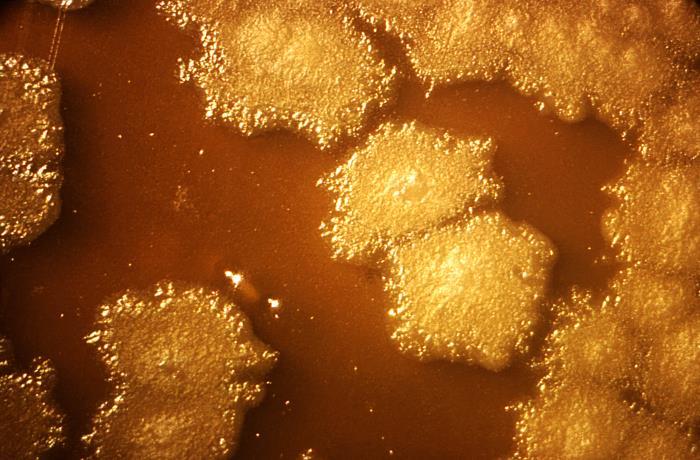

Daktaras demonstruoja vėžio ląsteles. Šaltinis: TechNaujienos / Shutterstock
Modifikuota bakterija „suvalgys“ vėžio navikus iš vidaus: mokslininkai skelbia naujienas
TRUMPAI
- • Kanados mokslininkai kuria genetiškai modifikuotą bakteriją, galinčią ardyti naviko struktūras jo viduje.
- • Tyrime pritaikytas mechanizmas leidžia kontroliuoti bakterijų aktyvumą ir jų atsparumą deguoniui.
- • Projektas pereina į ikiklinikinių bandymų etapą, vertinant metodo saugumą ir veiksmingumą.
Vaterlo universiteto (Kanada) tyrėjų komanda pristatė naują eksperimentinį metodą, kuriuo siekiama gydyti vėžį naudojant genetiškai modifikuotas bakterijas. Tyrimas paskelbtas kaip recenzuota publikacija, o šiuo metu ruošiamasi ir ikiklinikiniams bandymams. Mokslininkai teigia, kad šios naujos bakterijos galėtų ardyti solidinius navikus iš jų vidaus.
Projektui vadovauja cheminės inžinerijos profesorius dr. Marcas Aucoinas kartu su taikomosios matematikos profesoriumi dr. Brianu Ingallsu ir kitais tarpdisciplininės komandos nariais.
Kaip bakterijos prisitaiko prie naviko aplinkos
Tyrimo pagrindas – bakterija Clostridium sporogenes, natūraliai aptinkama dirvožemyje ir galinti augti tik visiškai deguonies neturinčioje aplinkoje. Būtent tokios sąlygos susidaro solidinių navikų centre, kur dėl sutrikusios kraujotakos trūksta deguonies, o audiniuose kaupiasi maistinės medžiagos.
Mokslininkų teigimu, bakterijų sporos gali patekti į naviką, ten sudygti ir pradėti daugintis. Taip jos kolonizuoja auglio vidų ir skaido jame esančias struktūras. Tačiau natūraliai ši bakterija žūva pasiekusi išorines naviko dalis, kur deguonies kiekis yra didesnis.
Genų inžinerija ir kontroliuojamas aktyvavimas
Siekiant išspręsti šią problemą, tyrėjai į bakteriją įterpė geną iš giminingos rūšies, kuris padidina atsparumą deguoniui. Tai leidžia mikroorganizmams išgyventi ilgiau naviko pakraščiuose.
Kad bakterijos nepradėtų daugintis deguonies turtingose vietose, pavyzdžiui, kraujyje, buvo sukurtas papildomas kontrolės mechanizmas, paremtas vadinamuoju kvorumo jutimu.
Šis biologinis procesas leidžia bakterijoms „įvertinti“ savo populiacijos dydį pagal išskiriamus cheminius signalus. Tik pasiekus pakankamą bakterijų koncentraciją navike, aktyvuojamas deguoniui atsparus genas.
Ankstesniame tyrime komanda parodė, kad Clostridium sporogenes gali būti modifikuota taip, kad toleruotų deguonį. Vėlesniame etape kvorumo jutimo sistema buvo išbandyta naudojant žalią fluorescencinį baltymą kaip aktyvavimo indikatorių.
Taip pat skaitykite: Farmacijos milžinė „Bayer“ turės išmokėti 7,25 mlrd. JAV dolerių kompensacijų herbicido „Roundup“ vėžio bylose
Tolimesni žingsniai link ikiklinikinių tyrimų
Kitas projekto etapas – sujungti atsparumo deguoniui geną ir kvorumo jutimo mechanizmą vienoje bakterijoje bei išbandyti ją ikiklinikiniuose modeliuose su navikais.
Tyrimas išaugo iš doktoranto Bahramo Zargaro darbo ir vykdomas bendradarbiaujant su Toronto įmone CREM Co Labs. Projekte dalyvauja chemijos inžinerijos, matematikos ir gyvybės mokslų specialistai.
Jei būsimi bandymai patvirtins metodo saugumą ir veiksmingumą, bakterijų pagrindu sukurta terapija galėtų tapti alternatyviu būdu taikyti gydymą solidiniams navikams, ypač tais atvejais, kai tradiciniai metodai yra riboti.
Kas yra solidinis navikas?
Solidiniai navikai – tai kieti, konkrečiame organe ar kūno vietoje susiformuojantys augliai, kurie sudaro apčiuopiamą
ar vaizdiniais tyrimais (KT, MRT) matomą darinį, pavyzdžiui, plaučių, krūties ar storosios žarnos vėžys; jie skiriasi
nuo kraujo vėžio formų, tokių kaip leukemija, kurios nesudaro atskiro audinio „guzelio“, o plinta kraujyje ar kaulų
čiulpuose.
Kaip vertinate šį straipsnį?
Prenumeruokite mūsų „YouTube“ kanalą ir mėgaukitės įdomiais vaizdo reportažais apie mokslą ir technologijas.
Trumpai, aiškiai ir be triukšmo – gaukite svarbiausias technologijų ir mokslo naujienas pirmieji.
DIENOS SKAITOMIAUSI
Simuliacijoje populiarūs DI modeliai kūrė virtualų pasaulį: vienas jų žlugo vos per 4 dienas
2Vienas garsiausių Vincento van Gogo darbų slepia paslaptį, kuri iki šiol glumina mokslininkus
3Pristatytas „Oura Ring 5“: drastiškai sumažintas dydis ir naujos DI funkcijos
4Savaitgalį pakelkite akis į Mėnulį: toks reginys nepasikartos iki pat 2053-ųjų
5Pavojingas „Windows“ spragas atskleidęs tyrėjas buvo užblokuotas: dėl „Microsoft“ veiksmų kilo ginčas
NAUJAUSI
Taip pat skaitykite
Atrinkome panašius straipsnius, kurie gali jums patikti.